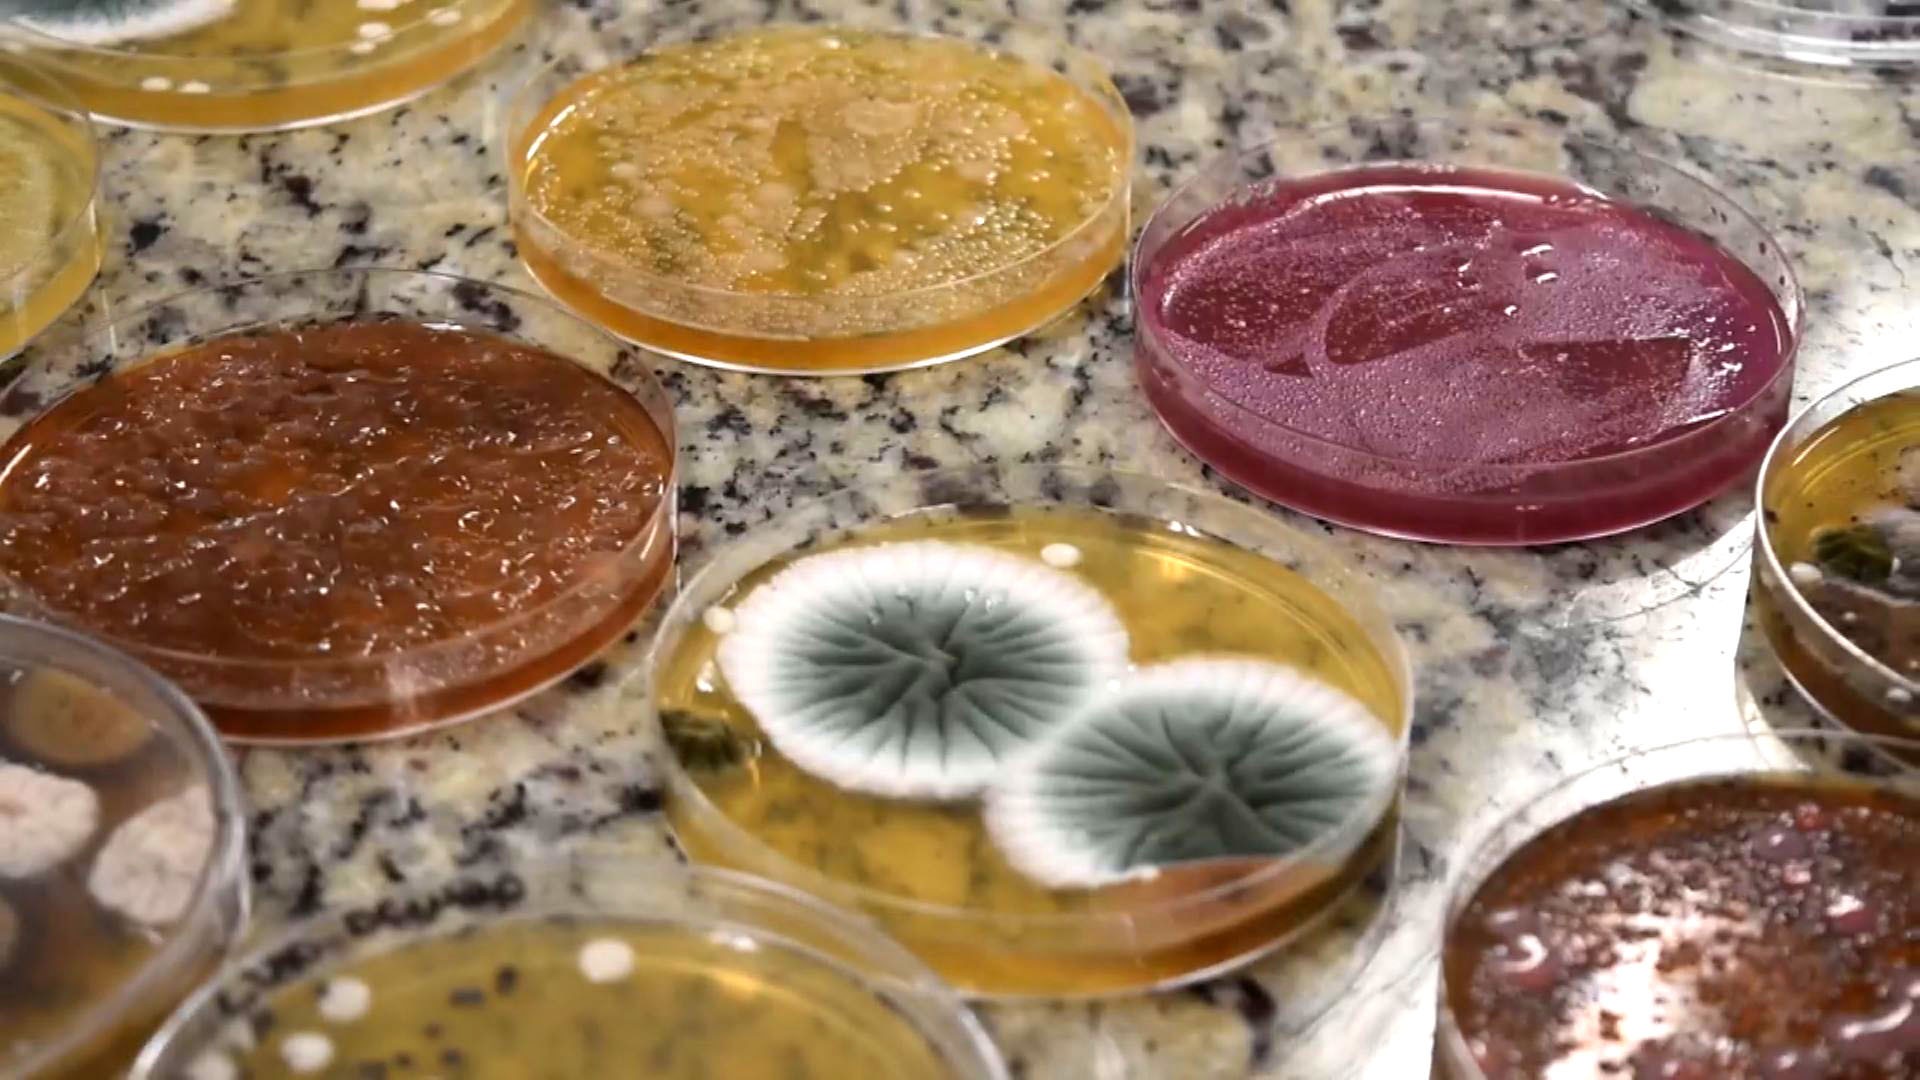

Pesquisa aponta alto risco de contaminação cruzada em 7 itens de pias de cozinhas; veja ranking
Estudo feito em Campinas encontrou milhões de bactérias e fungos em panos de pia, panos de prato, rodinhos, ralos, lixeiras de pia e outros produtos. Micro-organismos podem causar de diarreia a infecção urinária. Pesquisa de Campinas analisa contaminação de 7 itens de pias de cozinhas; ranking Se você é daqueles que acham que só trocar o saco da lixeirinha da pia, dar uma lavada rápida no paninho de pia, na esponja e na tábua de carne são suficientes, fique atento aos riscos de contaminação cruzada na sua cozinha. Uma pesquisa feita em Campinas (SP) analisou esses e outros produtos e encontrou milhões de fungos e bactérias prejudiciais à saúde, que podem causar desde diarreia a infecção urinária. O estudo durou três meses e foi conduzido pelo curso de biomedicina do Centro Universitário UniMetrocamp Wyden. Nove cozinhas de casas escolhidas aleatoriamente receberam as pesquisadoras para coleta de amostras de sete itens que ficam na bancada da pia. Ranking da contaminação Lixeira - 1,744 milhão de bactérias e 1.180 fungos Esponja de lavar louça - 1,322 milhão de bactérias e 440 fungos Ralo - 1,302 milhão de bactérias e 801 mil fungos Pano de pia - 1,200 milhão de bactérias e 4 mil fungos Pano de prato - 975 mil bactérias Rodo de pia - 242,7 mil bactérias e 15.750 fungos Tábua de carne - 16,4 mil bactérias e 8.170 fungos Milhões de fungos e bactérias encontrados em itens que ficam sobre a pia de cozinhas domésticas. Pesquisa foi feita em Campinas. Patrícia Teixeira/G1 Alguns dos micro-organismos identificados pela pesquisa foram E.Coli, Pseudomonas aeruginosa, Staphylococcus aureus, Klebsiella pneumoniae, Enterobacter aerogenes, Candida e Rhodotorula. "Se você esquece de lavar as mãos, isso acaba passando para o alimento. Se muitas vezes você vai consumir aquele alimento cru, que é uma verdura, um legume, que não vai sofrer cozimento, essas bactérias vão ser ingeridas por você durante a alimentação, e pode causar problemas desagradáveis", afirma a orientadora da pesquisa e doutora em ciências de alimentos Rosana Siqueira. Pessoas com imunidade baixa, crianças e idosos estão mais sujeitos a problemas de saúde por conta da exposição aos micro-organismos, segundo o estudo. Lixeira de pia de cozinha e rodo podem conter bactérias e fungos, aponta estudo de Campinas. Arquivo pessoal Os sintomas de contaminação pelos agentes identificados são: diarreia febre vômitos dores abdominais intoxicação alimentar dor de garganta infecção urinária Tábua de alimentos e ralo de pia merecem atenção quando o assunto é contaminação na cozinha. Pesquisa de Campinas encontrou bactérias e fungos. Patrícia Teixeira/G1 Ideal é lixeira no chão A lixeirinha chamou a atenção pela falta de higiene. Foram analisadas as partes externa, interna e a tampa. "Às vezes a gente passa a semana, meses, sem limpar o lixinho com água sanitária ou álcool, por falta de tempo e por não saber que tem tanto micro-organismo. Às vezes fica úmido e favorece bastante o crescimento. A maioria das pessoas acaba só trocando o saquinho", afirma a graduanda Fernanda Baptista. Fernanda também explica que o ideal é que as cozinhas domiciliares tenham a lixeira no chão, com pedal, para evitar o uso das mãos. Se for na pia, precisa ser bem limpa. "O lixinho fica no local onde é feita a manipulação do alimento, então a gente pode contaminar a mão e, assim, contaminar o alimento", explica a aluna Sarah Stocco, que também realizou as coletas e análises. A terceira integrante do estudo é a graduanda Julie Aki Mashima. Análise de amostra retirada de um dos itens contaminados na cozinha durante pesquisa feita em Campinas. Patrícia Teixeira/G1 Hora certa de descartar Cada item deve ser observado para verificar o momento de fazer o descarte. O ralo precisa ser lavado com água quente e, em caso de ficar muito desgastado, precisa trocar, segundo orientação da professora Rosana. "A tábua, quando você vê a presença de ranhuras, manchas, está na hora de trocar. As bactérias podem ficar acumuladas nessas ranhuras. E você usa para carne, para legumes". "As bactérias não resistem muito à água quente", explica. Aquele paninho "limpa tudo" deve ser descartado após o uso. Rosana orienta que, se for usado, ele seja recortado em tamanhos pequenos. "A gente acaba deixando úmido, isso favorece o desenvolvimento de micro-organismos. A gente não usa só na pia, mas para limpar o fogão e outros objetos. A gente fica trocando de lugar, da pia vai para a mesa, da mesa para o fogão". O pano de prato usado para secar a louça não deve ser o mesmo que enxuga as mãos. "Ficou úmido, já troque seu pano de prato para não ter o problema de contaminação". Pano de prato, esponja e paninho de pia concentram fungos e bactérias se não forem higienizados, segundo pesquisa de Campinas. Patrícia Teixeira/G1 Tanto o rodo quanto a esponja devem ser limpos e guardados secos. Rosana também alerta para que a louça não fique muito tempo acumulada na pia, principalmente em dias de calor. A alta temperatura aumenta a proliferação de fungos e bactérias. "Esses micro-organismos estão presentes no nosso dia a dia, na água, no solo, nos alimentos que a gente traz para a nossa casa. O importante é controlar esse crescimento", ressalta a pesquisadora. Como evitar a contaminação cruzada Higienização dos objetos precisa ser regular para reduzir a proliferação de bactérias e fungos na cozinha. Lixo deve ser retirado todos os dias da lixeira, principalmente à noite, para evitar ficar muito tempo armazenado. Sempre que possível, lavar a lixeira e a tampa (com água quente ou água sanitária) e deixar secar antes de colocar o saquinho. Ferver a esponja de lavar louça, ou colocar por 1 minuto em um pote de vidro com água no micro-ondas. Lavar tábua de carne, pia e ralo com água quente. Trocar os produtos de limpeza eventualmente. O uso excessivo do mesmo produto pode gerar maior resistência dos micro-organismos, que ficam imunes com o tempo. Da esq. para dir., a graduanda Fernanda Baptista, a orientadora Rosana Siqueira e a graduanda Sarah Stocco, da UniMetrocamp, em Campinas. Patrícia Teixeira/G1 Veja mais notícias da região no G1 Campinas
Texto completo










